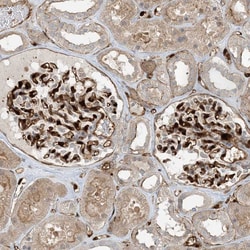
Invitrogen PPM1F Polyclonal Antibody 100 &mu;L; Unconjugated:Antibodies,

missing translation for 'onlineSavingsMsg'
Learn More
Learn More
Invitrogen™ PPM1F Polyclonal Antibody
Rabbit Polyclonal Antibody
Brand: Invitrogen™ PA556609
This item is not returnable.
View return policy
Description
Immunogen sequence: LDTLLQDFPA LLNPEDPLPW KAPGTVLSQE EVEGELAELA MGFLGSRKAP PPLAAALAHE AVSQLLQTDL SEFRKLPRE Highest antigen sequence identity to the following orthologs: Mouse - 73%, Rat - 77%.
PPM1F is a member of the PP2C family of Ser/Thr protein phosphatases. PP2C family members are known to be negative regulators of cell stress response pathways. This phosphatase can interact with Rho guanine nucleotide exchange factors (PIX), and thus block the effects of p21-activated kinase 1 (PAK), a protein kinase mediating biological effects downstream of Rho GTPases. Calcium/calmodulin-dependent protein kinase II gamma (CAMK2G/CAMK-II) is found to be one of the substrates of this phosphatase. The overexpression of this phosphatase or CAMK2G has been shown to mediate caspase-dependent apoptosis.
Specifications
| PPM1F | |
| Polyclonal | |
| Unconjugated | |
| PPM1F | |
| 1110021B16Rik; 4933427B07Rik; Ca(2+)/calmodulin-dependent protein kinase phosphatase; calcium/calmodulin-dependent protein kinase phosphatase; caM-kinase phosphatase; CAMKP; CaMKPase; FEM-2; hFem-2; KIAA0015; mKIAA0015; Partner of PIX 2; partner of PIX2; POPX2; PP2C phosphatase; Ppm1f; Protein fem-2 homolog; protein phosphatase 1F; protein phosphatase 1F (PP2C domain containing); protein phosphatase, Mg2+/Mn2+ dependent 1F; protein phosphatase, Mg2+/Mn2+ dependent, 1F | |
| Rabbit | |
| Antigen affinity chromatography | |
| RUO | |
| 9647 | |
| Store at 4°C short term. For long term storage, store at -20°C, avoiding freeze/thaw cycles. | |
| Liquid |
| Immunohistochemistry (Paraffin), Western Blot, Immunocytochemistry | |
| 0.2 mg/mL | |
| PBS with 40% glycerol and 0.02% sodium azide; pH 7.2 | |
| P49593 | |
| PPM1F | |
| Recombinant protein corresponding to Human PPM1F. Recombinant protein control fragment (Product #RP-95346). | |
| 100 μL | |
| Primary | |
| Human | |
| Antibody | |
| IgG |
Product Content Correction
Your input is important to us. Please complete this form to provide feedback related to the content on this product.
Product Title
Spot an opportunity for improvement?Share a Content Correction